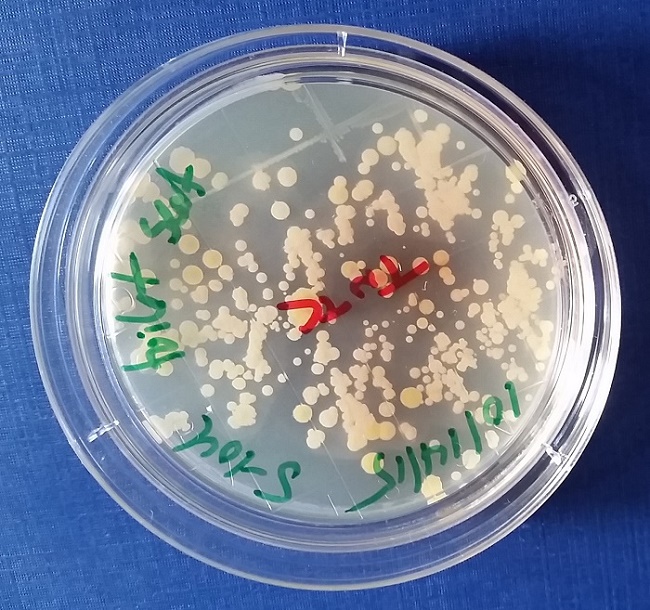

Welcome! Log into your account
Recover your password
Pan-Access Global Collective.
Join. Contribute. Make A Difference.
ISSN 2369-7342
Join. Contribute. Make A Difference.
ISSN 2369-7342
Contact us: [email protected]
© Copyright 2015-2026. www.IC.tips. All Rights Reserved